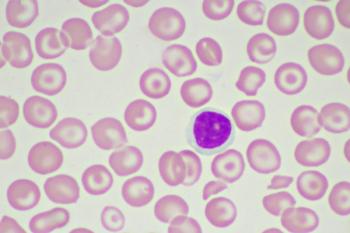
jarun011-stock.adobe.com

CVS Caremark will continue to manage specialty drug benefits for Tyson Foods.

Joseph M. Shields talks about the formation of Transparency-Rx and its goals of achieving PBM reform that focuses on “corrective steps to address the misalignment in the marketplace to ensure that there’s competition and choice.”

Coverage of contraceptives and contraceptive care without cost-sharing is required under the Affordable Care Act.

Current treatments for urea cycle disorders, which causes ammonia to build up in the blood, have a bitter taste and smell. Pheburane was developed with a special coating that masks the taste of sodium phenylbutyrate. It has a list price of $4,375 per bottle.

Peter Rubin of No Patient Left Behind worries that patients may not see benefits, either in lowered costs or continued investment in new therapies, from drug price negotiations required under the Inflation Reduction Act.

Airsupra is an anti-inflammatory rescue medication that can treat the symptoms of asthma while helping to prevent an attack.

Balversa targets FGFR3 genetic alterations and is approved as a second-line treatment for in adult patients with metastatic urothelial carcinoma.

Regulators are warning about the increased risk of very low blood calcium levels in patients with advanced chronic kidney disease.

Last year saw the approval of several firsts, including the first vaccines to prevent respiratory syncytial virus in older adults and infants and a first vaccine to prevent the mosquito-borne virus chikungunya.

A 2020 rule stands in which copay assistance from pharmaceutical companies counts toward deductibles for brand name drugs without a generic competition.

IQVIA’s most recent Global Use of Medicines report projected that market introductions of new biosimilar and generic drugs will increase projected losses for originator products from $111 billion to $192 billion over the next five years.

HyQvia is now available a maintenance therapy for adults with chronic inflammatory demyelinating polyneuropathy, which can lead to weakness and loss of feeling in the arms and legs.
With a cost of $2.2 million, Casgevy is a CRISPR/Cas9 gene-edited cell therapy that is now also approved to treat beta thalassemia. It was approved to treat sickle cell disease in December 2023.

Adstiladrin delivers a gene that encodes for the interferon alpha-2b protein, and it provides an option for those at high risk of recurrence and metastatic bladder cancer.

Less flexible plans, such as health maintenance organizations, are more likely to use biosimilar therapies than more flexible plans.

UnitedHealth Group executives attribute the increase of revenue at Optum Rx to the addition of new clients, expanded relationships with existing clients, and advancements in services.

Regulators will continue to evaluate a possible link by reviewing meta-analysis of clinical trials across all GLP-1 products and analyzing postmarketing data in the Sentinel System.

Vevye is a water- and preservative-free solution of cyclosporine, which allows for improved bioavailability.

Clients are cautious about how the cost in “cost-plus” programs is determined, how rebates factor in and the benchmarks used, says Navitus’s Brent Eberle.

The transaction is valued at about $575 million. The sale is part of Rite Aid’s restructuring plan after filing for bankruptcy in October 2023.

Tivdak was granted accelerated approval in September 2021 to treat patients with recurrent or metastatic cervical cancer. The goal date for full approval is May 9, 2024.

The FDA cited issues with a third-party manufacturing company. Zolbetuximab is being reviewed to treat patients with stomach cancer.

Zelsuvmi, a first-in-class topical treatment approved for patients with molluscum contagiosum, will be available in the second half of 2024.

Adam Fein, founder of Drug Channels, said the acquisition will allow the company to upgrade its technology, grow the company and provide live and in-person events.

If approved, Accord’s biosimilar would treat several autoimmune conditions and would be launched no later than May 15, 2025

CVS Caremark has entered into an agreement with AbbVie, the manufacturer of Humira, to supply Cordavis with Humira to develop a cobranded product. Cordavis is a CVS company developing private label therapies.